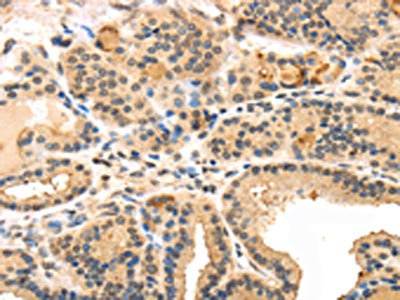

-
中文名稱:TUSC5兔多克隆抗體
-
貨號:CSB-PA098304
-
規格:¥1100
-
圖片:
-
The image on the left is immunohistochemistry of paraffin-embedded Human liver cancer tissue using CSB-PA098304(TUSC5 Antibody) at dilution 1/40, on the right is treated with synthetic peptide. (Original magnification: ×200)
-
The image on the left is immunohistochemistry of paraffin-embedded Human thyroid cancer tissue using CSB-PA098304(TUSC5 Antibody) at dilution 1/40, on the right is treated with synthetic peptide. (Original magnification: ×200)
-
Gel: 12%SDS-PAGE,Lysate: 40 μg,Lane 1-2: Lovo cells, 231 cells,Primary antibody: CSB-PA098304(TUSC5 Antibody) at dilution 1/200 dilution,Secondary antibody: Goat anti rabbit IgG at 1/8000 dilution,Exposure time: 40 seconds
-
-
其他:
產品詳情
-
Uniprot No.:
-
基因名:TUSC5
-
別名:TRARG1; IFITMD3; LOST1; TUSC5; Trafficking regulator of GLUT4 1; Dispanin subfamily B member 1; DSPB1; Interferon-induced transmembrane domain-containing protein D3; Protein located at seventeen-p-thirteen point three 1; Tumor suppressor candidate 5
-
宿主:Rabbit
-
反應種屬:Human,Mouse,Rat
-
免疫原:Synthetic peptide of Human TUSC5
-
免疫原種屬:Homo sapiens (Human)
-
標記方式:Non-conjugated
-
抗體亞型:IgG
-
純化方式:Antigen affinity purification
-
濃度:It differs from different batches. Please contact us to confirm it.
-
保存緩沖液:-20°C, pH7.4 PBS, 0.05% NaN3, 40% Glycerol
-
產品提供形式:Liquid
-
應用范圍:ELISA,WB,IHC
-
推薦稀釋比:
Application Recommended Dilution ELISA 1:2000-1:5000 WB 1:500-1:2000 IHC 1:30-1:150 -
Protocols:
-
儲存條件:Upon receipt, store at -20°C or -80°C. Avoid repeated freeze.
-
貨期:Basically, we can dispatch the products out in 1-3 working days after receiving your orders. Delivery time maybe differs from different purchasing way or location, please kindly consult your local distributors for specific delivery time.
-
用途:For Research Use Only. Not for use in diagnostic or therapeutic procedures.
相關產品
靶點詳情
-
功能:Regulates insulin-mediated adipose tissue glucose uptake and transport by modulation of SLC2A4 recycling. Not required for SLC2A4 membrane fusion upon an initial stimulus, but rather is necessary for proper protein recycling during prolonged insulin stimulation.
-
基因功能參考文獻:
- Aberrant DNA hypermethylation of TUSC5 in breast cancer suggests epigenetic mechanism of cancer associated down-regulation PMID: 23302999
- These findings may point to participation of Tusc5 in shared adipose-nervous system functions. PMID: 17689857
-
亞細胞定位:Cell membrane; Single-pass membrane protein. Endomembrane system; Single-pass membrane protein. Cytoplasm, perinuclear region.
-
蛋白家族:CD225/Dispanin family
-
組織特異性:Expressed at high levels in heart, mammary gland, adrenal gland, stomach, smooth muscle and skeletal muscle, and at lower levels in brain and lung. Strongly down-regulated in lung cancer tissues, due to hypermethylation of the corresponding locus. Express
-
數據庫鏈接:
Most popular with customers
-
-
YWHAB Recombinant Monoclonal Antibody
Applications: ELISA, WB, IHC, IF, FC
Species Reactivity: Human, Mouse, Rat
-
Phospho-YAP1 (S127) Recombinant Monoclonal Antibody
Applications: ELISA, WB, IHC
Species Reactivity: Human
-
-
-
-
-